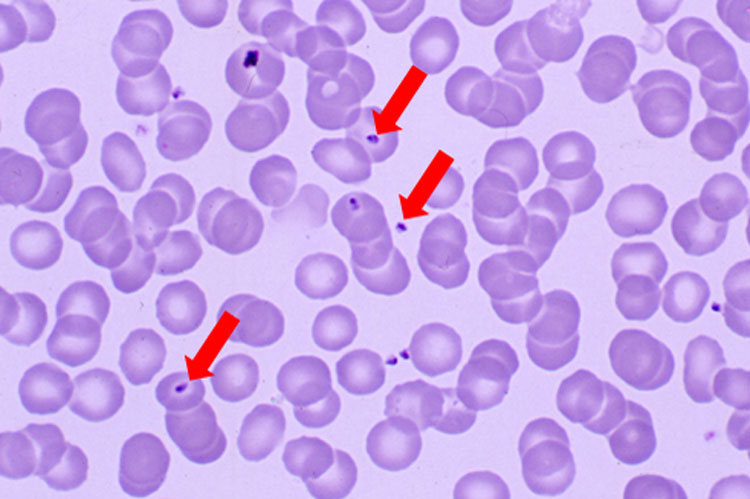

ম্যালিগন্যান্ট ম্যালেরিয়ায় মৃত্যুর ভয়কে এ বার তা হলে সত্যি-সত্যিই জয় করা যাবে? আর আক্রান্তও হতে হবে না ম্যালেরিয়ায়?
সেই আলোর দিশা দেখাল হালের একটি গবেষণা। দেখাল, মশা কামড়ালে তার লালার সঙ্গে ঠিক কোন পথে শরীরে ঢোকে ম্যালেরিয়ার বাহক এককোষী জীব বা প্রোটোজোয়া প্লাসমোডিয়াম ফ্যালসিপেরাম। জানাল, ঠিক কোন ‘চাবি’ দিয়ে কোষের কোথায় ‘তালা খুলে’ ঢুকে পড়ে সেই প্রোটোজোয়ারা। গবেষণা এও দেখাল, সেই এককোষী জীব কী ভাবে দেহে ছড়িয়ে পড়ে কাঁপুনি দিয়ে প্রবল জ্বর ডেকে আনে। এই প্রথম। ‘ক্রায়ো-ইলেকট্রন মাইক্রোস্কোপি’র সর্বাধুনিক পদ্ধতিতে।
এর ফলে, ম্যালেরিয়া প্রতিরোধে অদূর ভবিষ্যতে অত্যন্ত সফল টিকা বাজারে আসতে পারে, বলছেন বিশেষজ্ঞরা। ৫০ বছর পার হয়ে গেলেও যে ধরনের টিকা এখনও আসেনি বাজারে। কোনও ওষুধও বেশি দিন তার সাফল্য ধরে রাখতে পারেনি, কারণ, কিছু দিন সেই ওষুধ ব্যবহারের পর, পরজীবীরা তার কার্যকরী ক্ষমতাকে প্রতিরোধ করতে শিখে গিয়েছে। ফলে, নিত্যনতুন ওষুধ আবিষ্কারের গবেষণা চলছে। চলবেও।

তথ্যসূত্র: ‘হু’-র রিপোর্ট (২০১৮)
গবেষণাপত্রটি প্রকাশিত হয়েছে আন্তর্জাতিক বিজ্ঞান-জার্নাল ‘নেচার’-এর গত ১২ ডিসেম্বর সংখ্যায়। মেলবোর্নের ওয়াল্টার অ্যান্ড এলিজা হল ইনস্টিটিউটের দুই অধ্যাপক অ্যালান কাওম্যান ও উইলসন ওং-এর নেতৃত্বে ওই আন্তর্জাতিক গবেষকদলে রয়েছেন দুই অনাবাসী ভারতীয় প্যারাসাইটোলজিস্ট অনন্ত শ্রীবাস্তব ও অনিন্দিতা ঘোষ সেন। তাঁরা আমেরিকার হাওয়ার্ড হিউজেস মেডিক্যাল ইনস্টিটিউটের জ্যানেলিয়া রিসার্চ ক্যাম্পাসের গবেষক।
ম্যালেরিয়া: গত বছর বিশ্বে আক্রান্ত ২২ কোটি মানুষ!
পুরোপুরি সফল টিকা বা ওষুধ বেরয়নি বলেই ভারত, আফ্রিকা ও পূর্ব ভূমধ্যসাগরীয় এলাকা-সহ গোটা বিশ্বের ম্যালেরিয়া পরিস্থিতি নিয়ে ফি-বছরই উদ্বেগজনক রিপোর্ট দিতে হয় বিশ্ব স্বাস্থ্য সংস্থা (‘হু’)-কে। সেই রিপোর্ট বলছে, গত বছর বিশ্বে ম্যালেরিয়ায় আক্রান্ত হয়েছেন ২১ কোটি ৯০ লক্ষ মানুষ। মৃতের সংখ্যা ৪ লক্ষ ৩৫ হাজার। ভারত ও আফ্রিকার দেশগুলির অবস্থা রীতিমতো ভয়াবহ। গত বছর ভারতে ম্যালেরিয়ায় আক্রান্ত হয়েছেন ৮ লক্ষ ৪৪ হাজার ৫৫৮ জন মানুষ। মৃতের সংখ্যা ১৯৪।

তথ্যসূত্র: ‘হু’-র রিপোর্ট (২০১৮)
ম্যালেরিয়ার বাহক প্রোটোজোয়াদের হাতে থাকা সেই ‘চাবি’টা কী?
দুই অন্যতম গবেষক অনন্ত শ্রীবাস্তব ও অনিন্দিতা ঘোষ সেন ‘আনন্দবাজার ডিজিটাল’কে জানিয়েছেন, ওই চাবিটা রয়েছে এককোষী জীব প্লাসমোডিয়াম ফ্যালসিপেরামের দেহের বাইরের দেওয়ালে থাকা তিনটি প্রোটিনের হাতে।
সেই প্রোটিনগুলি হল- ১) ‘আরএইচ-৫’, ২) ‘সিওয়াই-আরপিএ’ এবং, ৩) ‘আরআইপিআর’।
এরাই আমাদের রক্তের লোহিত কণিকার (আরবিসি) কোষের বাইরের দেওয়ালে থাকা ‘তালা’টা খুলে ফেলে। সেই তালাটাও একটি প্রোটিন। তার নাম- ‘বাসিজিন’।
আরও পড়ুন- মশাকে বন্ধ্যা করলেই ডেঙ্গি-ম্যালেরিয়া নির্মূল, দাবি বাঙালি বিজ্ঞানীর
প্রথমে লোহিত কণিকার বাইরের দেওয়ালে গিয়ে লেগে থাকে (অ্যাটাচমেন্ট) ওই এককোষী জীব। হাতে চাবি নিয়ে তালাটা খুঁজতে থাকে।
কী ভাবে শরীরে ছড়ায় ম্যালেরিয়ার বাহক এককোষী জীব, দেখুন ভিডিয়ো
এই গবেষণার অভিনবত্ব কোথায়?
এত দিন জানা ছিল, এককোষী জীবের বাইরের দেওয়ালে থাকা তিনটি প্রোটিনই এক সঙ্গে তালাটা খুলে ফেলে।
কিন্তু ক্রায়ো-ইলেকট্রন মাইক্রোস্কোপে এই প্রথম দেখা গেল, মূলত একটি প্রোটিনের হাতেই থাকে সেই চাবি। তার নাম- ‘আরএইচ-৫’। তালাটা খুলতে সুবিধে হবে বলে সে সঙ্গে নেয় আরও একটি প্রোটিনকে। তার নাম- ‘সিওয়াই-আরপিএ’। আর তালা খোলার কাজটা যাতে আরও তাড়াতাড়ি হয়, তার জন্য ‘তেল’ জোগায় অন্য প্রোটিনটি। যার নাম- ‘আরআইপিআর’। আসলে তালা খোলার ক্ষেত্রে অনেকটা অণুঘটকের মতো কাজ করে প্রোটিন ‘আরআইপিআর’।
এও দেখা গিয়েছে, আমাদের লোহিত রক্ত কণিকার বাইরের দেওয়ালের যে কোনও জায়গায় গেলেই ঢুকতে পারে না ম্যালেরিয়ার জন্য দায়ী ওই এককোষী জীব। ‘তালা’টা থাকে লোহিত কণিকার বাইরের দেওয়ালের ‘জেকে-ওয়ান পয়েন্ট’-এ। সেখানেই থাকে বাসিজিন প্রোটিন। ম্যালেরিয়ার জন্য দায়ী এককোষী জীবকে ঢুকে পড়ার জন্য ওই বাসিজিন প্রোটিনই দরজাটা হাট করে খুলে দেয়।
মশার কামড়ের পর কী ভাবে শরীরে ঢোকে, ছড়ায় সেই প্রোটোজোয়ারা?

কলকাতার বিশিষ্ট ম্যালেরিয়া বিশেষজ্ঞ, স্কুল অফ ট্রপিক্যাল মেডিসিনের প্রাক্তন অধিকর্তা ও অধুনা সেন্টার ফর ট্রপিক্যাল মেডিসিন অ্যান্ড প্যারাসাইটোলজির অধিকর্তা অমিতাভ নন্দী জানাচ্ছেন, ম্যালেরিয়া একটি পরজীবী (প্যারাসাইট) জনিত অসুখ। যা এক জন মানুষ থেকে অন্য জন মানুষে ছড়ায় স্ত্রী অ্যানোফিলিস মশার মাধ্যমে। এদের মোট তিন ধরনের জীবন চক্র হয়। তাদের একটি হয় মশার শরীরে। পরজীবীদের বাকি দু’টি জীবন চক্র হয় আমাদের শরীরে। আমাদের শরীরে ওই পরজীবীদের দু’টি জীবন চক্রে মধ্যে একটি হয় লিভারে। অন্যটি হয় লোহিত রক্ত কণিকায়।
স্ত্রী অ্যানোফিলিস মশা কামড়ালে তার লালার সঙ্গে আমাদের শরীরে ঢোকে ওই পরজীবীরা। তারা রক্তস্রোতের মাধ্যমে সোজা গিয়ে পৌঁছয় আমাদের লিভারে। সেকানে কিছু দিনের মধ্যেই তার বংশবৃদ্ধি করতে থাকে। সেখান থেকে মেরোজয়েট দশায় থাকা অসংখ্য পরজীবী ঢুকে পড়ে রক্তস্রোতে। সেখান থেকে রক্তের লোহিত কণিকা (আরবিসি)-য় ঢুকে পড়ে তারা। সেখানে তাদের আরও একটি জীবন চক্র শুরু হয়। তাতে তাদের দ্রুত বংশবৃদ্ধি হয়। তার ফলে, অত্যন্ত চাপে লোহিত রক্ত কণিকার দেওয়াল ফেটে যায়। তখন সেগুলি ফের ঢুকে পড়ে রক্তস্রোতে। একই সঙ্গে রক্তে ঢুকিয়ে দেয় নানা ধরনের বিষাক্ত পদার্থ। তখনই কাঁপুনি দিয়ে আমাদের জ্বর আসে। যাকে আমরা ম্য়ালেরিয়ার লক্ষণ বলে জানি।
সেই জ্বর কখনও ৪৮ ঘণ্টায় আসে বা ৫২/৭২ ঘণ্টা পর। কেন?
অমিতাভ বলছেন, ‘‘রক্তের লোহিত কণিকায় একের পর এক জীবন চক্র হয় ওই পরজীবীদের। তাদের প্রত্যেকটি জীবন চক্র ৪৮ থেকে ৭২ ঘণ্টার মধ্যে শেষ হয়। একটি জীবন চক্র শেষ হলেই পরের জীবন চক্রটি শুরু হয়ে যায়। প্রতিটি জীবন চক্রের শেষে আমাদের কাঁপুনি দিয়ে জ্বর আসে। পরে রোনও ম্যালেরিয়া রোগীকে কোনও স্ত্রী অ্যানোফিলিস মশা কামড়ালে, রক্তের সঙ্গে সেই পরজীবীরা চলে যায় মশার পেটে। সেখানে তাদের নতুন জীবন চক্র (স্পোরোজয়েট) শুরু হয়। সেই মশা অন্য কোনও মানুষকে মানুষকে কামড়ালে, তিনিও তখন ম্য়ালেরিয়ার পরজীবীর দ্বারা সংক্রামিত হন।’’
ম্যালেরিয়ার বাহক চার ধরনের প্রোটোজোয়া রয়েছে। প্লাসমোডিয়াম ভাইভ্যাক্স, প্লাসমোডিয়াম ফ্যালসিপেরাম, প্লাসমোডিয়াম ওভিলি এবং প্লাসমোডিয়াম ম্যালেরি। তাদের মধ্যে প্লাসমোডিয়াম ফ্যালসিপেরামের হানাদারিতেই হয় সেই ভয়ঙ্কর ম্যালিগন্যান্ট টার্শিয়ান ম্যালেরিয়া (এমটিএম) বা, ম্যালিগন্যান্ট ম্যালেরিয়া।
রক্তের লোহিত কণিকায় ঢুকে পড়া প্লাসমোডিয়াম ফ্যালসিপেরাম (লাল তিরচিহ্নিত)
কল্যাণী বিশ্ববিদ্যালয়ের প্রাণীবিজ্ঞানের অবসরপ্রাপ্ত এমেরিটাস অধ্যাপক সমীরণ চক্রবর্তী বলছেন, ‘‘এই গবেষণা অবশ্যই একটি নতুন দিশা দেখিয়েছে। যে হেতু এই প্রথম নির্দিষ্ট ভাবে দেখা গিয়েছে কোন চাবিটা দিয়ে এককোষী জীবগুলি তালা খোলে, তাই অব্যর্থ টিকা বা ওষুধ আবিষ্কারের পথটা এ বার খুলে গেল।’’
৫০ বছরের গবেষণার পরেও কেন চালু হয়নি ম্যালেরিয়ার টিকা?
অমিতাভ জানাচ্ছেন, সাতের দশক থেকেই বাজারে ম্যালেরিয়ার বিভিন্ন টিকা নিয়ে গবেষণা, পরীক্ষানিরীক্ষা হয়েছে। এখনও হচ্ছে। কিন্তু অব্যর্থ টিকা বানিয়ে তা চালু করা সম্ভব হয়নি এখনও পর্যন্ত। গবেষণায় দেখা গিয়েছে, তাদের সাফল্যের হার ছিল কম-বেশি ৩৫/৪০ শতাংশ। সেই সব টিকা বাণিজ্যিক ভাবে ব্যবহারের জন্য তার উপাদান জোগাড় করাটা ছিল কষ্টসাধ্য। ব্যয়সাপেক্ষও। ফলে, ম্যালেরিয়া নির্মূল করতে তা তেমন গ্রহণযোগ্য হয়ে উঠতে পারেনি।
আরও পড়ুন- ডেঙ্গির ফাঁকে ম্যালেরিয়াও
‘‘কিন্তু এই টিকা চালু হলে তার সাফল্যের হার অনেকটাই বেশি হতে পারে’’, বলছেন অমিতাভ ও সমীরণ।
এই গবেষণাকে কোন কোন ভাবে কাজে লাগানো যেতে পারে?
অমিতাভ ও সমীরণ দু’জনেই জানাচ্ছেন, ‘‘টিকা বা ওষুধের মাধ্যমে ওই আরএইচ-৫ প্রোটিনকে রুখে দিয়ে বা বেঁধে ফেলে (ব্লক বা বাইন্ড ) বা মেরে ফেলে (কিল) এ বার হয়তো ম্যালেরিয়ার জন্য দায়ী এককোষী জীবগুলিকে আমাদের শরীরে লড়াইয়ে সত্যি-সত্যিই হারিয়ে দেওয়া যাবে।’’
তার জন্য অবশ্য হিউম্যান ট্রায়াল পর্যন্ত অপেক্ষা করতে হবে আমাদের, এমনটাই বলছেন কলকাতার বিশেষজ্ঞরা।
গ্রাফিক: শৌভিক দেবনাথ ও তিয়াসা দাস
গ্রাফিক-তথ্য: অমিতাভ নন্দী, সমীরণ চক্রবর্তী









